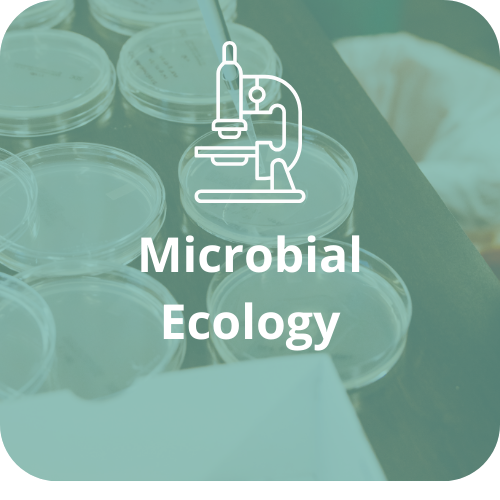
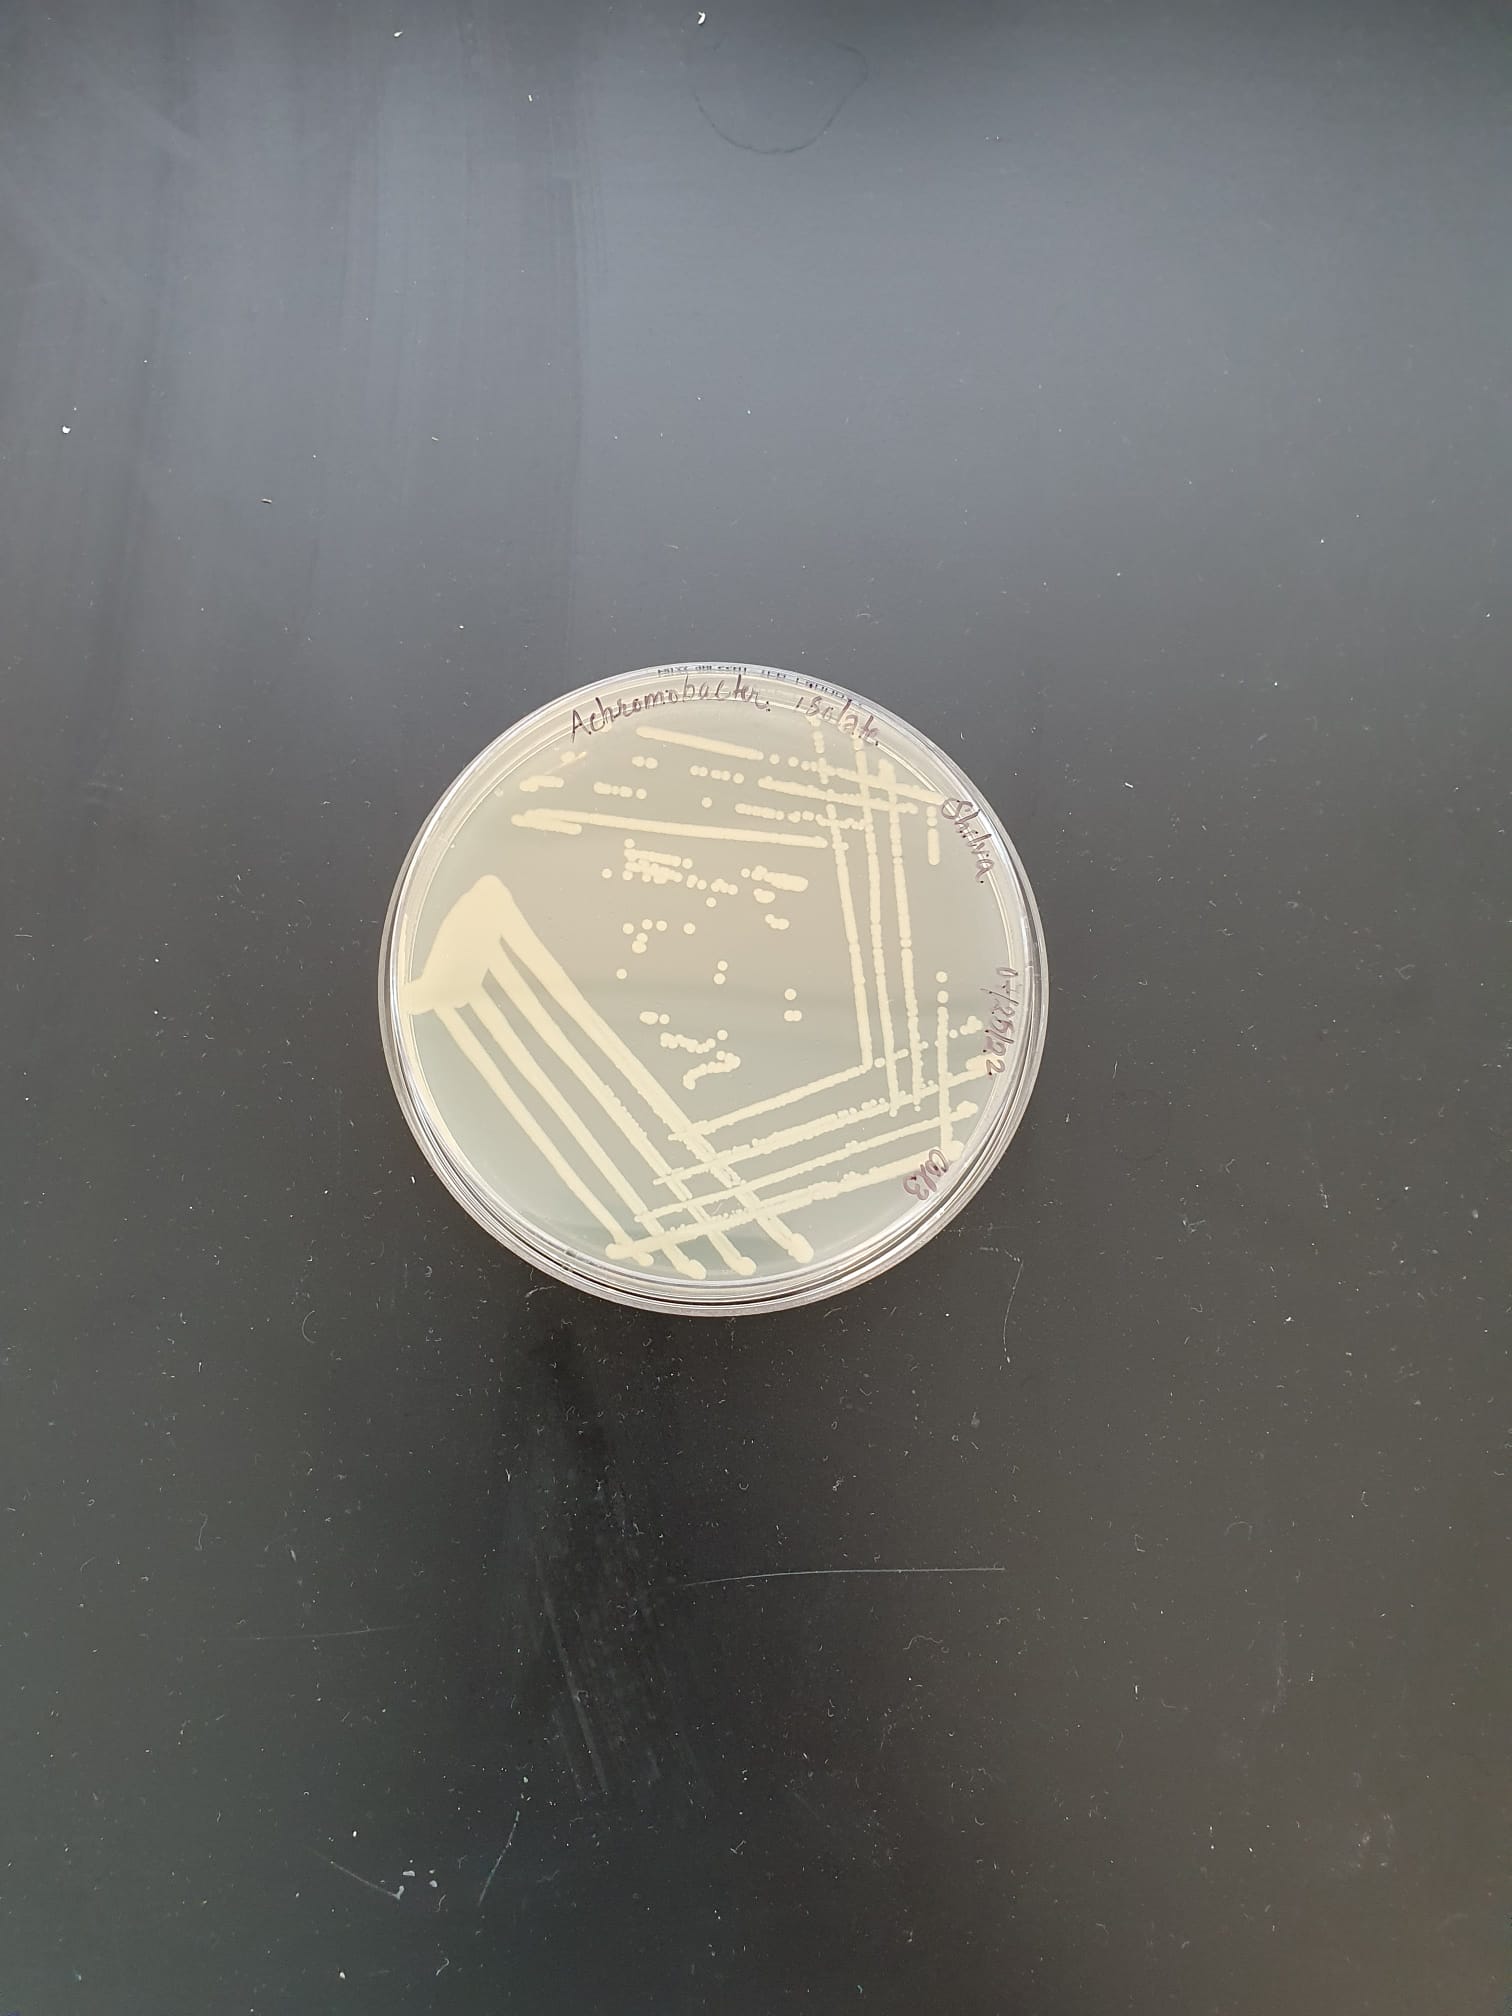

The overarching goal of our research is to harness the power of microbes to recover valuable energy, chemicals, and materials from biomass to achieve a sustainable circular carbon economy. We combine laboratory experimentation with computational analysis at the interface of environmental and chemical engineering, microbiome engineering, and modeling.

Bioengineered Systems for Resource Recovery



We develop and optimize anaerobic bioreactor systems to recover high-value products, including carboxylic acids, alcohols, and bioplastics, from organic waste streams and lignocellulosic biomass. Specifically, biofilm bioreactors such as anaerobic dynamic membrane bioreactors are attractive for biological wastewater treatment and resource recovery due to their enhanced microbial activity, high volumetric production rate, low cost, and low energy requirements.
Microbiome Engineering
We employ top-down and bottom-up approaches to microbiome engineering to design robust and resilient microbial consortia capable of efficiently degrading biomass to target products. Using state-of-the-art molecular and computational biology tools, we focus on understanding the underlying microbial dynamics and interactions in microbial consortia to inform process optimization and hence improve the overall performance of the bioengineered systems.